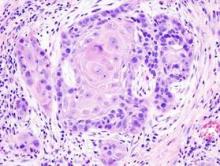

Lapatinib in combination with platinum-based chemoradiotherapy and as long-term maintenance therapy showed no benefit in patients with surgically treated high-risk squamous cell carcinoma of the head and neck (SCCHN).
No difference was observed between treatment arms in the primary endpoint of disease-free survival (DFS) or the secondary endpoints of investigator-assessed DFS and overall survival.
“Certainly, these findings should serve as a note of caution on the risks of initiating large phase III studies (of this and other drugs) with insufficient evidence of single-agent activity,” wrote Dr. Kevin Harrington of the division of radiotherapy and imaging at the Institute of Cancer Research and Royal Marsden Hospital, London, and his colleagues (Journ Clin Onc. 2015 Nov. 2. doi: 10.1200/JCO.2015.61.4370).
The placebo-controlled phase III trial from 84 sites in 21 countries randomized 688 patients with resected SCCHN to receive placebo or lapatinib. The study was halted early because of the apparent plateauing of DFS events at the median follow-up time of 35.3 months, the investigators reported.
DFS events (disease recurrence or death) occurred in 32% of patients who received placebo versus 35% of patients who received lapatinib (HR, 1.10; 95% CI, 0.85-1.43; P = .45). No significant differences in DFS were observed between treatment arms by human papillomavirus or EGFR status.
Lapatinib is a small-molecule inhibitor of epidermal growth factor receptor (EGFR) and human epidermal growth factor receptor 2 (HER2) and was postulated to be active in squamous cell carcinoma of the head and neck tumors because many overexpress EGFR. Lapatinib has shown efficacy in HER2-positive metastatic breast cancer, but not in other EGFR-driven cancers.
Compliance was high in both placebo and lapatinib arms, with 83% and 76%, respectively, achieving greater than 80% compliance. Adverse events of grade 3 or higher were observed in 67% of the placebo arm and 75% of the lapatinib arm. The most common grade 3 or 4 adverse events were lymphopenia and mucosal inflammation.